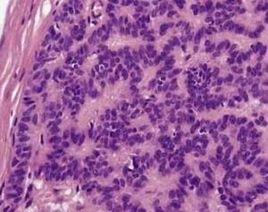
汗腺腺瘤

簡介
汗腺腺瘤
英文名稱
syringoma
別名
eccrine syringocystadenoma;eruptiva hidroadenoma;syringocysadenoma;syringocystoma;syringo-hidroadenoma;發疹性汗腺瘤;管狀汗腺瘤;汗管汗腺瘤;汗管囊瘤;汗管囊腺瘤;汗管瘤;小汗腺汗腺腺瘤
ICD號
M8407/0
分類
腫瘤科 > 皮膚腫瘤 > 皮膚附屬器腫瘤
皮膚科 > 皮膚腫瘤 > 皮膚附屬器腫瘤
普通外科 > 皮膚腫瘤 > 皮膚良性腫瘤 > 表皮及其附屬器瘤及囊腫
病因
1.與遺傳有關 本病是一種痣樣腫瘤,有時有家族史。
2.可能與內分泌失調有關。
發病機制
組織化學研究證明汗腺腺瘤含典型小汗腺起源的磷酸化酶和水解酶。在真皮上部和中部可見許多囊狀導管和一些實性表皮細胞索,包埋於纖維基質中。囊狀導管壁常襯以兩層細胞,大都扁平。內層細胞偶呈空泡狀。一些導管的外壁細胞向外凸出彎曲,形如逗號或蝌蚪樣。在連續切片中,可見這些囊性導管與表皮內導管的擴張囊相連,但不與下方的大汗腺分泌段相連。
臨床表現
好發部位
下眼瞼及頰部。頸側、胸部也較為常見。亦可見於腰、背、四肢及生殖器等處。
臨床症狀
呈皮膚色,淡黃色或褐黃色,隆起性斑塊,圓形、卵圓形或不規則形,表面光滑或附有油膩物,呈蠟樣光澤,邊界清楚,其上無毛髮,也可呈疣狀或乳頭狀增生,半球形或扁平丘疹,通常多發,直徑一般為數毫米,多數密集而不融合,常對稱分布於下眼瞼,亦可見於額部、兩頰和陰部。病程慢性,很少自行消退,通常無自覺症狀,有時可有瘙癢感,發生於女陰者可有劇癢。
此外尚有以下亞型
常與糖尿病伴發,臨床上皮損與汗腺腺瘤相同,年齡、性別及皮損分布亦無差別。兩病的差別除組織病理表現外,即常與糖尿病伴發;文獻報告60例中,僅1例不伴發糖尿病。亦有報告發疹性皮損者。
首先由Darier描述本病。本病組織學上與眼瞼汗腺腺瘤相同,但皮損呈發疹性,對稱分布於頸部、胸部、腋窩、上臂和臍周。皮損呈光澤性淡攻瑰色丘疹,頗似扁平苔蘚和二期梅毒疹。此亞類亦報告與Down綜合徵伴發,有家族性,亦見於具有透明細胞組織象的糖尿病婦女。本病臨床上可與Gougerot-carteaud網狀乳頭瘤病混淆。
個別病例臨床上表現不尋常性的汗腺腺瘤。包括限局於頭部,引起禿髮,呈單側線狀或痣樣分布;限局於女陰或陰莖;限局於遠端肢體;以及扁平苔蘚樣和栗丘疹樣等型。
病理檢查
組織病理檢查:真皮內可見很多小導管,其壁由兩排上皮細胞構成,大多扁平,但內排細胞偶或空泡化。導管腔含無定形物質,有些導管有小的逗點樣上皮尾巴,呈蝌蚪狀。此外尚見與導管無聯繫的嗜鹼性上皮細胞束。鄰近表皮處,可見囊樣導管腔,管腔內充滿角蛋白,囊壁襯以含透明角質顆粒的細胞。青春發育期的皮損中,真皮內可見大量成熟或接近成熟的皮脂腺,無皮脂腺導管,直接與毛囊漏斗相連,其上方的表皮呈疣狀或乳頭瘤樣增生。嬰兒及兒童期的皮損內僅有少許或無皮脂腺結構。
透明細胞汗腺腺瘤中通常的汗腺腺瘤巢與透明毛玻璃樣物質圍繞小而暗色卵圓形核的細胞巢混合存在。免疫組化分析角蛋白表達證明其為傳統性汗腺腺瘤的一種代謝性亞型(表1)。
鑑別診斷
根據臨床特點,汗腺腺瘤一般不難診斷。必要時取活檢組織病理免疫組化檢查明確診斷。
汗腺腺瘤有時需與扁平疣、黃色瘤、丘疹型環狀肉芽腫區別。必要時做病理檢查明確診斷。
瞼黃瘤
瞼黃瘤常見於上瞼近內眥處,為黃色丘疹或斑塊,常對稱分布。多見於中年以上婦女,常伴有高脂蛋白血症。
扁平疣
扁平疣主要見於青少年,多發生在面部,但下瞼非好發部位,除面部外,也可見於手背,為表面光滑,質硬,粉紅、淡黃、淺褐或正常膚色的芝麻至黃豆大小的扁平丘疹。散在或成群分布。一般無症狀,偶有疼痛感。可自行消失,組織病理可以確診。
疣狀痣
皮損可發生於身體任何部位,為淡黃色或棕黑色疣狀丘疹,表面角化過度,粗糙,多呈線狀分布。組織病理檢查為表皮角化過度,乳頭瘤樣增生,棘層肥厚,基底層黑素增多,但無疣細胞。
乳頭狀汗管囊腺瘤
乳頭狀汗管囊腺瘤多發於頭皮,皮損為單個乳頭瘤狀結節、斑塊,表面有滲出、結痂。組織病理檢查為表皮不同程度的乳頭瘤樣增生,並不規則地向真皮內陷形成乳頭狀囊腔。
幼年黑素瘤
幼年黑素瘤皮損為單發的粉紅色或紅褐色堅實結節,直徑1~2cm,表面光滑或疣狀隆起,外傷後易出血。
硬斑病型基底細胞上皮瘤
硬斑病型基底細胞上皮瘤皮損為扁平或略凹陷硬化淡黃色斑,光滑,表面有光澤,邊緣常不清楚。組織病理完全不同。
毛囊瘤
毛囊瘤皮損為多發的小圓形堅實丘疹和小結節,面部多見,向中心性分布,少數為單個發丘疹。
毛髮上皮瘤
毛髮上皮瘤好發於鼻唇溝處,丘疹較大,往往呈半球形,呈常染色體顯性遺傳,組織病理可以確診。
發疹性汗腺腺瘤
汗腺腺瘤應與丘疹性環狀肉芽腫和丘疹性梅毒疹鑑別,前者活檢呈漸進性壞死,後者梅毒血清反應陽性,皮疹可自行消退。
治療方法
可不予治療。影響外觀容貌時可採用下列治療方法。
1.手術治療。
2.非手術治療 可行電解、CO2雷射和液氮冷凍等治療。
預後
治療不徹底時,皮損可復發。
相關檢查
雌激素